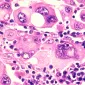

18/08/2022
Uzmanlar için haberler
Biocodex Microbiota Institute Haberler bölümüne hoş geldiniz! Öncü keşiflere bir bakış, mikrobiyota uzmanlarının analizleri, gelecekteki tıbbi ve bilimsel gelişmelerin gözden geçirilmesi - bu sayfa sağlık uzmanları için nihai kaynaktır. Bilginizi geliştirin ve siz de bir mikrobiyota elçisi olun.
Güncel kalın
Mikrobiyota topluluğuna katılın ve mikrobiyota hakkında en son haberler ile güncel kalmak için ayda bir "The Essential" ı alın.
Abone oldum